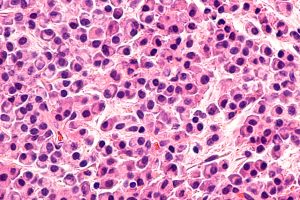

When Something Feels Off in Your Mouth or Jaw, We’re Here to Investigate
Not every unusual spot, lump, or sore in your mouth is serious—but some are. At Mahogany Oral Surgery, our team is specially trained to identify and manage a wide range of conditions that affect the head, neck, jaw, and oral tissues—from simple cysts to more complex concerns like oral cancer.
Getting answers early is the key to better outcomes and peace of mind.
What Should You Be Looking For?
Your mouth is lined with a soft, pink tissue called mucosa. When something changes—like color, texture, or sensation—it may be a sign that something’s not quite right.
Common warning signs include:
- A sore that doesn’t heal
- Red or white patches inside the mouth
- A lump, bump, or swelling
- Tissue that bleeds easily
- Persistent sore throat or hoarseness
- Difficulty swallowing or chewing
- Numbness or tingling in the face or mouth
- Changes in color, texture, or size of any oral tissue
If something feels off and hasn’t gone away in two weeks—get it checked.
What to Expect at Your Appointment
We’ll start with a gentle conversation and a detailed health history, followed by a clinical exam. Based on what we see, we may:
- Recommend imaging (ultrasound, CT scan, or MRI)
- Perform a biopsy (a small tissue sample) to confirm a diagnosis
If we find something that needs treatment, we’ll explain everything clearly—no jargon, no pressure. Our team will help you understand your options, including both surgical and non-surgical approaches.
Conditions We Evaluate and Treat
Our experienced surgeons can diagnose and manage:
- Oral cancer and precancerous lesions
- Jaw cysts and tumors (both benign and aggressive)
- Salivary gland conditions
- Infections in the face or jaw
- Immune-related oral conditions
- Facial pain or unexplained oral symptoms
Whether you’re dealing with a known concern or just want something evaluated for peace of mind, we’re here for you.
Want to Learn More?
Visit the Calgary Oral Surgery Group’s Head & Neck Pathology Page for a more detailed overview of conditions, diagnostics, and treatments.
Book a Consultation
If you or your dentist have noticed something unusual, don’t wait. Call Mahogany Oral Surgery to schedule a consultation. We’re here to provide answers—and the expert care you deserve.


